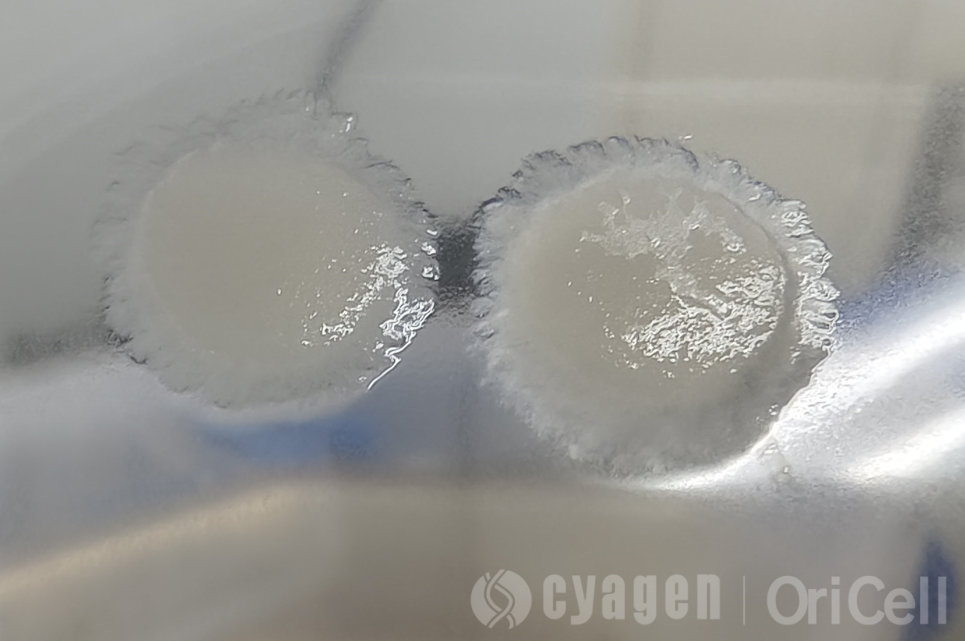
细胞真菌污染的主要特征

什么是细胞真菌性污染?主要来源特征是什么?细胞真菌性污染怎么处理?
菌丝像在培养液里“涮火锅”,悠哉游哉铺开绵长的网;酵母则仿佛偷偷“撒发酵粉”,让培养基暗起泡泡、泛起混浊,而你的细胞,正不知不觉沦为这场盛宴的“主菜”。
在细胞培养过程中,细胞污染是实验室常见的问题,严重影响实验结果的可重复性和细胞活性。那么,平时我们该如何辨别和预防「真菌污染」?本文为大家详细介绍真菌污染的症状及应对方法。
Part 1 细胞真菌性污染的定义
细胞真菌污染是指在细胞培养过程中,真菌(如酵母菌、霉菌等)意外侵入并在培养体系中增殖,导致细胞培养环境恶化,从而对细胞系的纯度、活性、代谢功能及实验数据的准确性与可靠性造成严重破坏的现象。
Part 2 细胞真菌污染的主要来源
实验环境(最常见和最主要的污染来源)
-
空气流通与灰尘:真菌孢子(如霉菌、酵母菌)非常轻小,可以长时间漂浮在空气中。实验室的人员流动、开关门、通风系统等都会造成空气流动,将外界环境中的孢子带入超净工作台或细胞间。
-
环境湿度和洁净度:细胞房如果湿度过高、清洁消毒不彻底,墙角、冰箱门封等潮湿处容易滋生霉菌,成为持久的污染源。
-
空调与通风系统:实验室的中央空调或通风管道如果未定期清洁和维护,会成为真菌孢子的“储存库”和“传播器”。
-
着装:未穿洁净服进入细胞房,外套曾接触过其他污染区域(如细菌培养室、公共走廊),可能携带孢子。
-
手部清洁:未彻底清洗双手或消毒不严格,尤其是在接触门把手、打印机、电脑等公共物品后。
-
谈话、咳嗽、打喷嚏:在超净台内或细胞房内,这些行为会喷出大量气溶胶,其中可能含有真菌。
-
动作过大过快:在超净台内快速移动手臂或物品,会扰乱台内的单向气流,导致台外未过滤的空气卷入工作区。
试剂与耗材
-
培养基与血清:配制的培养基污染、血清自身污染、添加剂开封后保存不当,都可能引入真菌。
-
消化酶与PBS:如果分装或使用不当,极易被污染。
-
实验耗材:如培养瓶、试剂瓶、移液器等,如果包装破损或生产过程中灭菌不彻底,也可能带来污染。
细胞本身污染
-
原代细胞:从动物或人体组织分离的原代细胞,操作过程中可能引入真菌。
-
交叉污染:被污染的细胞在传代或操作过程中,通过共用试剂、移液器或培养基,污染其他细胞系。
-
水浴锅:温暖静止的水是真菌和细菌生长的温床,如果不定期清洗消毒,污染风险极高。
-
冰箱与水纯化系统:4℃冰箱的冷凝水、水盘;纯水系统的滤膜、管路长期未维护,都可能滋生微生物。
-
显微镜与离心机:多人共用的设备,如果细胞样品泄漏,未及时清洁消毒,也可能成为污染源。
Part 3 细胞真菌污染的主要特征
肉眼观察(培养基)
-
浑浊:培养基出现云雾状或絮状浑浊,静置后可能可见沉淀或悬浮团块。
-
菌落形态:可见白色、淡黄色、黑色等絮状、绒毛状或粉末状的菌落漂浮在液面或附着在培养器皿底部/侧壁。
-
pH变化:培养基的pH值在污染初期变化不明显(与细菌污染导致培养基迅速变黄不同),但随着真菌大量生长,pH也可能发生改变。
典型真菌污染案例图示

显微镜观察
-
霉菌:可见典型的菌丝体,呈细长、分枝状的管状结构,相互交织成网状。
-
酵母菌:呈卵圆形或球形的单个细胞,通常能看到出芽生殖的现象。
典型真菌污染案例图示


生长速度与模式
-
生长速度:污染迹象的出现通常比细菌污染慢一些,初期难以发现。
-
生长模式:霉菌污染常呈 “菌落式”生长,从一个点逐渐向外扩展;而酵母菌则会使培养基整体变得均匀浑浊(云雾状)。
-
细胞状态:细胞生长速度显著减慢,形态变差,胞内颗粒增多,最终大量死亡、脱落。
-
营养竞争:真菌与细胞争夺培养基中的营养物质和生长因子。
-
代谢物毒性:真菌分泌的代谢产物可能改变培养环境pH,并对细胞产生毒性作用。
Part 4 细胞真菌性污染的处理办法
立即废弃与彻底消毒
(首选方案)
-
立即将污染的培养物从培养箱和超净工作台中取出,用封口膜封住瓶盖,确保密封。
-
对所有污染的细胞瓶/皿、培养基、接触过的枪头等,如是一次性耗材,全部作为生物危险废弃物丢弃,或选择高温灭菌。
-
超净工作台:用含有效氯的消毒剂或75%酒精彻底擦拭台面、内壁和所有内部设备。随后开启紫外线灯照射1小时以上。
-
立即清空培养箱,移除所有其他细胞,用高浓度消毒剂(如含氯消毒液、专用杀孢子剂)彻底擦拭箱体内壁、隔板、水盘和所有传感器。
-
检查所有在操作中可能使用过的试剂,如胰酶、PBS、培养基等,任何已开封、怀疑被污染的试剂,最安全的做法是灭菌后丢弃。
-
更换无菌水,并定期清洁水盘。
推荐处理办法
绝大多数污染,特别是霉菌污染
立即废弃,彻底消毒。这是最安全、最经济、对实验室其他细胞最负责的做法。
污染细胞独一无二,价值极高
在严格隔离下尝试挽救,使用抗真菌药物处理,需多次传代与监测,但须接受成功率不高、耗时耗力、且对细胞本身有毒性影响的风险。挽救成功后,该细胞系也应与其他细胞隔离培养。
细胞房常备清单——抗生素产品推荐
- OriCell®青霉素-链霉素溶液 (100X),货号ATPS-10001
- OriCell®青霉素-链霉素-两性霉素B溶液 (100X),货号APSB-10001
- OriCell®青霉素-链霉素-庆大霉素溶液 (100X),货号APSG-10001
- OriCell®支原体清除试剂 (100X),货号MPRA-10201
填写需求描述给我们
工具快速咨询
400-680-8038
info@oricellbio.cn